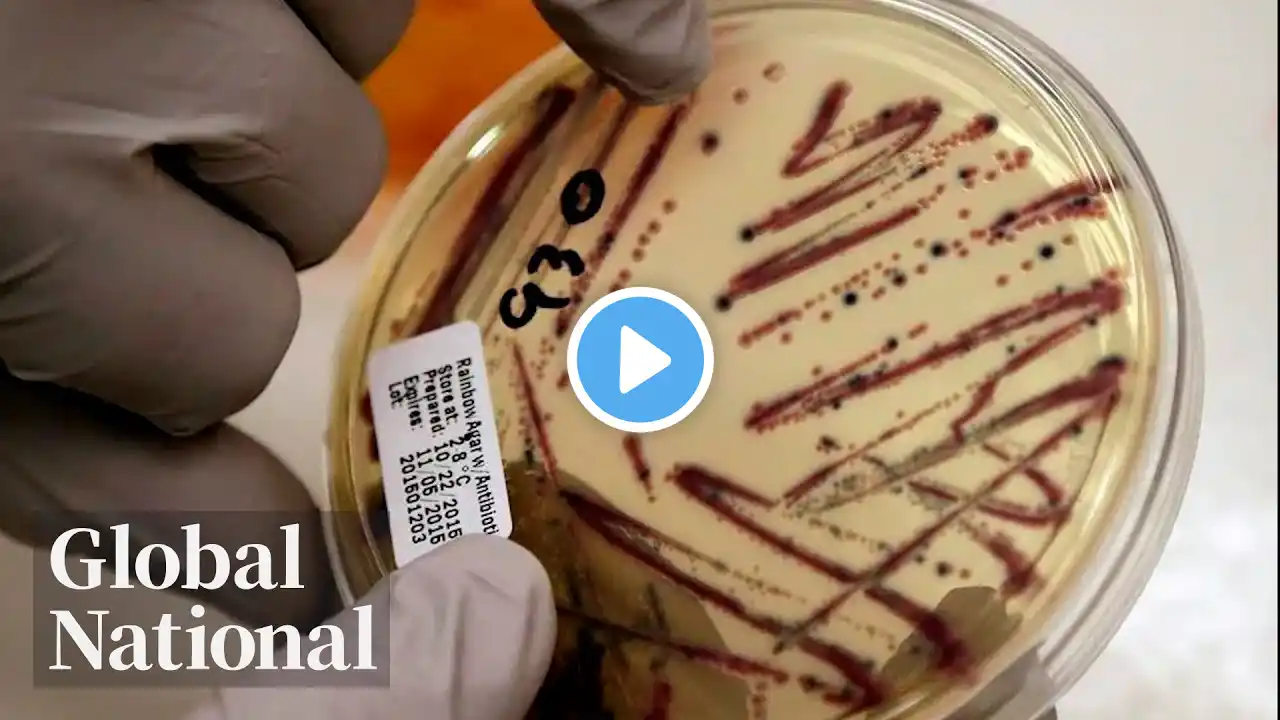
ภาพตัวอย่างวิดีโอ

Global National: March 8, 2023 | Pressure grows on Trudeau to address to foreign interference claims
Prime Minister Justin Trudeau is under growing pressure to answer questions regarding what he knew about allegations of Chinese interference in Canada's democratic process. Mackenzie Gray reports on the heat Trudeau is taking from the opposition, and the Privy Council documents suggesting senior government officials were warned about intelligence showing Chinese government officials were covertly funnelling money to Canadian political candidates. A House of Commons committee has roasted the top executives of Canada's largest grocery store chains about their rising prices and record profits, as more shoppers struggle to pay for food. David Akin explains how CEOs were put on the hot seat and on notice, how they politely pushed back, and the unimpressive solutions they presented. In Ontario, an Indigenous child protection agency called Nogdawindamin is being praised for its innovative approach. Carolyn Jarvis looks at how its leader has been unrelenting in his quest to keep Indigenous children in their communities. Also, Heather Yourex-West explains the growing anger in Alberta after an oilsands leak was kept secret from the public for months. Plus, Global’s Shogofa Danish reports on the intensifying danger for women risking their lives to work as journalists in Afghanistan. And, Eric Sorensen explains why the European Space Agency says it's about time the moon had its own time zone. For more info, please go to https://globalnews.ca/national/progra... Subscribe to Global News Channel HERE: http://bit.ly/20fcXDc Like Global News on Facebook HERE: http://bit.ly/255GMJQ Follow Global News on Twitter HERE: http://bit.ly/1Toz8mt Follow Global News on Instagram HERE: https://bit.ly/2QZaZIB #GlobalNews #globalnational